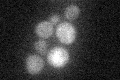
YAL012W
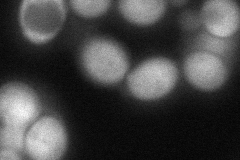
YAL012W

View description
Cystathionine gamma-lyase, catalyzes one of the two reactions involved in the transsulfuration pathway that yields cysteine from homocysteine with the intermediary formation of cystathionine
Localization:
Intensity:
Fold change:
Significance:
-
C’ GFP library in SD
below threshold18.91 -
N' NOP1pr-GFP in SD

cytosol230.12 -
N' TEF2pr-mCherry in SD

cytosol430.905 -
N' NATIVEpr-GFP in SD

cytosol174.01 -
N' TEF2pr-VC and Cyto-VN in SD
cytosol84.6736 -
C’ GFP library in SD+DTT

cytosol16.70.88No -
C’ GFP library in SD+H2O2

cytosol18.220.96No -
C’ GFP library in Starvation Media

cytosol22.641.19No -
C’ GFP library on the background of Pup2-DaMP

below threshold -
C’ GFP library on the background of CCT mutant

below threshold20.59151.08851No
